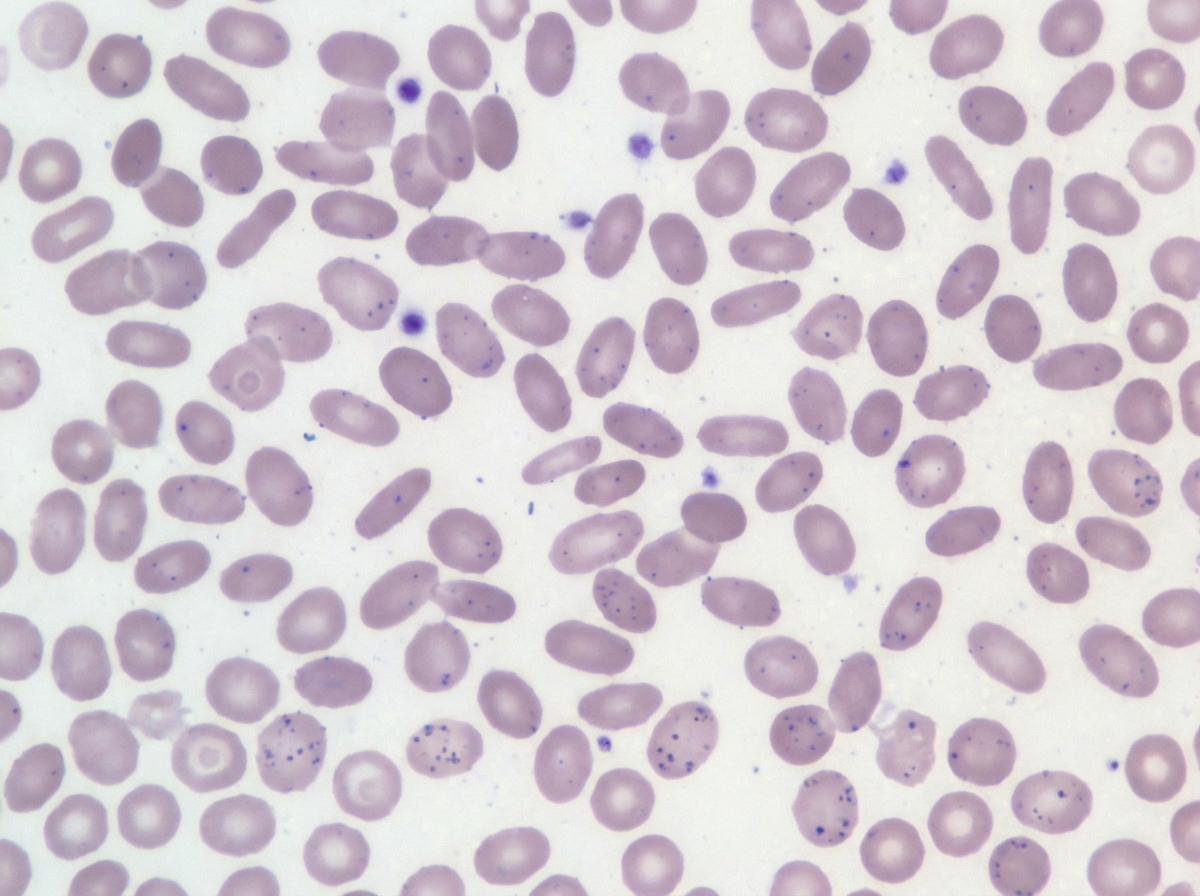
Image for question 104

Enter your email to get your 85% OFF code and unlock the full USMLE question bank on the app.
A 42-year-old man presents to a free dermatology clinic, complaining of itchy skin over the past several days. He has no insurance and lives in a homeless shelter. The patient has no significant medical history. Physical evaluation reveals 2 mm erythematous papules and vesicles on his back and groin, with linear excoriation marks. Careful observation of his hands reveals serpiginous, grayish, threadlike elevations in the superficial epidermis, ranging from 3–9 mm in length in the webbing between several digits. What should be the suggested treatment in this case?
A 22-year-old man presents with abdominal cramps and diarrhea over the last few weeks. He notes that several of his bowel movements have a small amount of blood. Past medical history is significant for an intermittent cough that has been persistent since returning from Mexico last month. The patient takes no current medications. On physical examination, there is diffuse tenderness to palpation. Which of the following medications is indicated for this patient’s condition?
A 38-year-old woman is diagnosed with a stage IIIa infiltrating ductal carcinoma involving the left breast. The tumor is ER/PR positive, HER-2 negative, poorly differentiated Bloom-Richardson grade 3. 4/20 regional nodes are positive. The patient undergoes a lumpectomy with axillary lymph node dissection, followed by chemotherapy and radiation therapy to the left breast and axilla. Her chemotherapy regimen involves doxorubicin, cyclophosphamide, and paclitaxel. Following completion of the intensive phase, she is started on tamoxifen as an adjuvant therapy. 6 months later, she presents with increasing fatigue, orthopnea, and paroxysmal nocturnal dyspnea. Physical examination reveals the presence of an S3 gallop, jugular venous distension (JVD), pedal edema, and ascites. She is diagnosed with congestive cardiac failure and admitted for further management. An echocardiogram confirms the diagnosis of dilated cardiomyopathy with severe systolic dysfunction and an ejection fraction of 10%. Her medical history prior to the diagnosis of breast cancer is negative for any cardiac conditions. The baseline echocardiogram prior to starting chemotherapy and a 12-lead electrocardiogram were normal. Which of the following is most likely responsible for her current cardiac condition?
A 23-year-old man college student visits the Health Services Office complaining of an intense and painful rash involving his axillae, waist, periumbilical skin, and inner thighs. The pruritus is worse at night. He noticed the rash and onset of symptoms after a recent fraternity party 4 weeks ago. The physical examination is unremarkable, except for multiple excoriated small papules with burrows distributed in a serpiginous pattern. An image of the lesions is shown below. Which of the following best describes the mechanism of action of the first-line agent for this patient’s condition?

A 56-year-old man comes to the physician for a follow-up examination. Two weeks ago, he was treated for an acute gout attack of the metatarsophalangeal joints of his right big toe. His symptoms improved with naproxen. He has had three other similar episodes of joint pain in his toes and ankles during the last year that improved with over-the-counter analgesics. He does not currently take any medications. He used to drink 3–5 beers daily but has recently cut down. He is a chef at a steakhouse. His temperature is 37.0°C (98.6°F), pulse is 76/min, and blood pressure is 147/83 mm Hg. Examination of his right big toe shows minimal tenderness; there is no warmth or apparent deformity. The remainder of the examination shows no abnormalities. His serum creatinine concentration is 0.9 mg/dL. Long-term treatment with which of the following drugs is most appropriate to prevent future gout attacks?
A 7-year-old boy is brought to the pediatrician by his parents for concern of general fatigue and recurrent abdominal pain. You learn that his medical history is otherwise unremarkable and that these symptoms started about 3 months ago after they moved to a different house. Based on clinical suspicion labs are obtained that reveal a microcytic anemia with high-normal levels of ferritin. Examination of a peripheral blood smear shows findings that are demonstrated in the figure provided. Which of the following is the most likely mechanism responsible for the anemia in this patient?
A 67-year-old woman who was recently diagnosed with Crohn disease comes to the physician for evaluation of her immunosuppressive therapy. She has had recurrent flares since her diagnosis. Physical examination shows two shallow ulcers on her oral mucosa. The physician considers adding azathioprine to her medication regimen. A deficiency of which of the following enzymes would diminish the therapeutic effect of this drug?
A 75 year-old gentleman presents to the primary care physician with a 2 week history of right sided achilles tendon pain. He states that the pain has had a gradual onset and continues to worsen, now affecting the left side for the past 2 days. He denies any inciting event. Of note the patient performs self-catheterization for episodes of urinary retention and has been treated on multiple occasions for recurrent urinary tract infections. What is the most important next step in management for this patient's achilles tendon pain?
A 32-year-old woman, gravida 2, para 1, at 20 weeks' gestation comes to the physician for a prenatal visit. She feels well. Her first pregnancy was uncomplicated and the child was delivered vaginally. Medications include folic acid and an iron supplement. Her temperature is 37°C (98.6°F), pulse is 98/min, respirations are 18/min, and blood pressure is 108/76 mm Hg. Abdominal examination shows a uterus that is consistent with a 20-week gestation. The second-trimester scan shows no abnormalities. The patient intends to travel next month to Mozambique to visit her grandmother. Which of the following drugs is most suitable for pre-exposure prophylaxis against malaria?
A 54-year-old woman presents for follow-up care for her type 2 diabetes mellitus. She was diagnosed approximately 2 years ago and was treated with dietary modifications, an exercise regimen, metformin, and glipizide. She reports that her increased thirst and urinary frequency has not improved with her current treatment regimen. Her hemoglobin A1c is 8.5% at this visit. She is started on a medication that will result in weight loss but places her at increased risk of developing urinary tract infections and vulvovaginal candidiasis. Which of the following is the mechanism of action of the prescribed medication?
Antiparasitic drugs (antiprotozoals)
Practice Questions
Antimalarial medications
Practice Questions
Anthelmintics
Practice Questions
Antiseptics and disinfectants
Practice Questions
Antimicrobial stewardship principles
Practice Questions
Empiric antimicrobial selection
Practice Questions
Antimicrobial dosing in special populations
Practice Questions
Antimicrobial pharmacokinetics/pharmacodynamics
Practice Questions
Antimicrobial toxicities
Practice Questions
Antimicrobial allergies and cross-reactivity
Practice Questions
Combination antimicrobial therapy
Practice Questions
Cost-effective antimicrobial strategies
Practice Questions
New antimicrobial development
Practice Questions
Get full access to all questions, explanations, and performance tracking.
Scan to download app